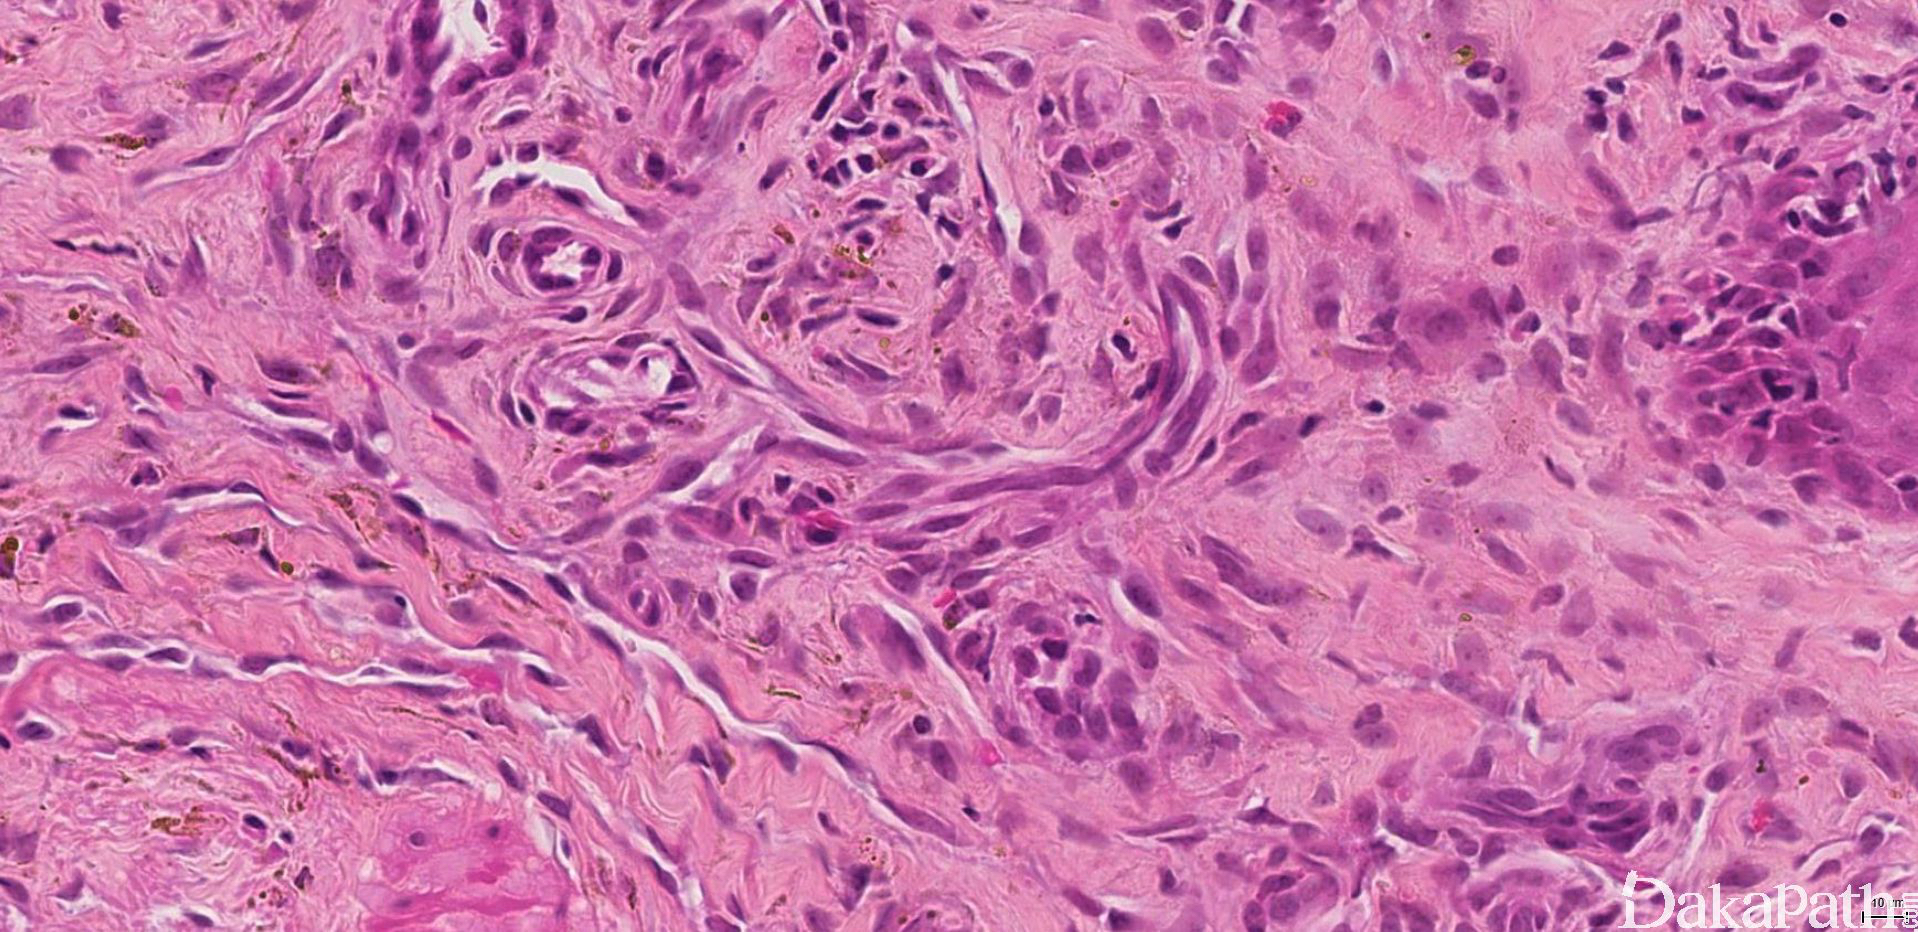

Kaposi 肉瘤
Kaposi sarcoma
同义词(或曾用名): 皮肤特发性多发性色素性肉瘤,多发性血管肉瘤,多发性出血性肉芽肿
概述:
与 HHV-8 病毒感染密切相关的一种中间型血管肿瘤
发病部位: 多发于老年男性,常见于下肢皮肤,可伴溃疡形成,也可累及淋巴结及内脏,大体观呈紫红或棕红色斑块或结节.
诊断要点:
- 多发于老年男性,常见于下肢皮肤,可伴溃疡形成,也可累及淋巴结及内脏,大体观呈紫红或棕红色斑块或结节;临床上分慢性地方性型、淋巴结病型、移植相关型和 AIDS 相关型四种临床类型。
典型的卡波西肉瘤细胞无明显的异型性,核分裂像也不多见,但少数病例中瘤细胞分化较差,异型性明显,可见较多的核分裂像。依据病变进展分为四期:
I 期:皮肤病变无特征性,仅为微血管增生;
II 期为斑点(斑片)期:变化极似肉芽组织,真皮血管数量增加,形状不规则,在真皮浅层胶原纤维间呈疏松、参差不齐的分支状排列,将真皮胶原纤维分隔。血管周梭形细胞增生、红细胞外渗,间质中淋巴细胞、浆细胞浸润,伴含铁血黄素沉着。
III 期为斑块期:皮肤轻度隆起,病变累及真皮全层或累及皮下组织。与 II 期形态学有明显的重叠,血管增生更广泛,红细胞外渗和含铁血黄素沉着更显著。管腔轮廓呈锯齿状,真皮血管周围嗜酸性梭形细胞增多,炎细胞浸润明显,可见大量的红细胞外渗,含铁血黄素及玻璃样小体。
IV 期为结节期:结节期的病变边界清楚,主要由网状或裂隙状的毛细血管及其周围纵横交错的嗜酸性梭形细胞组成,梭形细胞有一定异型性,核分裂偶见;梭形细胞和血管之间为含有红细胞的裂隙,横切面呈筛孔状或蜂窝状,在梭形细胞内或细胞外可见抗淀粉酶消化 PAS 阳性的嗜伊红色透明小体,结节的边缘常见炎症细胞浸润、含铁血黄素沉着和扩张的血管。 典型的卡波西肉瘤细胞无明显的异型性,核分裂像也不多见,但少数病例中瘤细胞分化较差,异型性明显,可见较多的核分裂像。
- 银染见网状纤维分布于梭形细胞之间并围绕血管腔隙;

免疫组织化学染色:
vimentin、ERG、CD31. CD34. VEGFR-3. FLI-1. PAL-E、抗 E92. FKBPl2. D2-40 阳性。无论哪种类型的 Kaposi 血管肉瘤均显示 HHV8 的相关性,玻璃样小球免疫组化染色表达 HHV8, PAS 染色阳性(耐淀粉酶消化)。CK,SMA 阴性。
鉴别诊断:
Kaposi 型血管内皮瘤:好发于婴幼儿和儿童,可见肾小球样结构,瘤组织呈多结节状,向周围浸润性生长,但周围无炎细胞浸润;
梭形细胞血管瘤 :病变内常见小灶或成串的上皮样内皮细胞,且病变常有明显的海绵状血管瘤样区域,而无明确的炎细胞浸润及含铁血黄素沉积;
纤维肉瘤 :梭形细胞间无裂隙状血管,无红细胞外渗和透明小体,肿瘤周边无增生扩张的血管或淋巴管,免疫表型不表达血管内皮标记。
预后:
取决于机体免疫功能、疾病所处阶段及有无感染等因素。
参考文献:
Calabresi A et al: Incidence of AIDS-defining cancers and virus-related and non-virus-related non-AIDS-defining cancers among HIV-infected patients compared with the general population in a large health district of northern Italy, 1999-2009. HIV Med. 14(8):481-90, 2013
Yanik EL et al: Recent cancer incidence trends in an observational clinical cohort of HIV-infected patients in the US, 2000 to 2011. Infect Agent Cancer. 8(1):18, 2013
